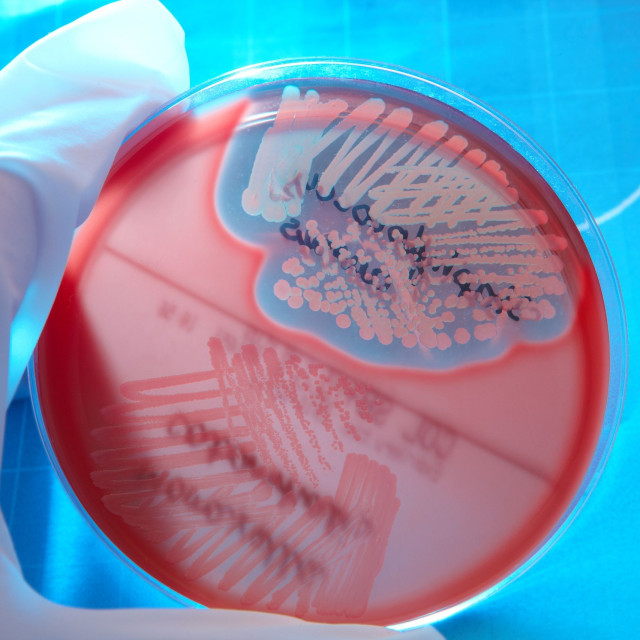
Λοίμωξη από σταφυλόκοκκο: Πρώιμα σημάδια - Τι να κάνετε αμέσως

Λοίμωξη από σταφυλόκοκκο: Πρώιμα σημάδια - Τι να κάνετε αμέσως
Συμπτώματα σταφυλοκοκκικής λοίμωξης: Μην αγνοήσετε ποτέ αυτά τα συμπτώματα.
Τα βακτήρια του σταφυλόκοκκου συχνά ζουν ακίνδυνα στο δέρμα, αν εισέλθουν στο εσωτερικό μέσω ενός κοψίματος ή λόγω εξασθενημένου δερματικού φραγμού, μπορούν να προκαλέσουν λοίμωξη εκπληκτικά γρήγορα.
Η δυσκολία έγκειται στο ότι τα πρώιμα συμπτώματα είναι συχνά ήπια και εύκολα αγνοούνται. Η έγκαιρη αναγνώρισή τους και η γρήγορη δράση μπορεί να αποτρέψει πιο σοβαρές επιπλοκές.
Τι είναι η σταφυλοκοκκική λοίμωξη;
Ο σταφυλόκοκκος αναφέρεται σε μια ομάδα βακτηρίων, συνηθέστερα τον Staphylococcus aureus, που μπορεί να προκαλέσει λοιμώξεις, οι οποίες κυμαίνονται από μικρά δερματικά προβλήματα έως σοβαρές συστημικές ασθένειες. Συνήθως εισέρχονται στο σώμα μέσω:
- Τομών ή εκδορών
- Θυλακίων τρίχας
- Χειρουργικών τραυμάτων
- Ιατρικών συσκευών (σε πιο σοβαρές περιπτώσεις)
Ποια είναι τα πρώτα σημάδια μιας σταφυλοκοκκικής λοίμωξης;
Τα πρώιμα συμπτώματα εμφανίζονται συνήθως στο δέρμα, αλλά μπορούν να εξελιχθούν εάν δεν αντιμετωπιστούν:
- Κόκκινη, πρησμένη περιοχή δέρματος: Μια μικρή κηλίδα ερυθρότητας που είναι ζεστή στην αφή και σταδιακά μεγαλώνει. Αυτό είναι συχνά το πρώτο ορατό σημάδι.
- Πόνος ή ευαισθησία: Η περιοχή μπορεί να γίνει επώδυνη ή ευαίσθητη στην αφή. Ο πόνος αυξάνεται αντί να μειώνεται με την πάροδο του χρόνου και είναι συχνά δυσανάλογος με το μέγεθος της αρχικής βλάβης.
- Πύον ή εξογκώματα γεμάτα με υγρό: Συνήθεις πρώιμες εκδηλώσεις περιλαμβάνουν σπυράκια, που επιδεινώνονται αντί να επουλώνονται και μικρά αποστήματα. Η παρουσία πύου είναι ισχυρός δείκτης βακτηριακής λοίμωξης.
- Δέρμα που είναι ζεστό ή φλεγμονώδες: Η τοπική θερμότητα αντανακλά την ανοσολογική απόκριση του οργανισμού στην λοίμωξη.
- Ήπιος πυρετός (σε ορισμένες περιπτώσεις): Μπορεί να εμφανιστεί χαμηλός πυρετός εάν η λοίμωξη αρχίσει να εξαπλώνεται.
Ποια συμπτώματα συχνά υποτιμώνται;
Ορισμένα σημάδια θεωρούνται ήπια, αλλά μπορούν να υποδηλώνουν επιδείνωση της λοίμωξης:
- Ένα «σπυράκι» που συνεχίζει να αναπτύσσεται
- Ερυθρότητα που εξαπλώνεται πέρα από το αρχικό σημείο
- Αυξανόμενος πόνος αντί για βελτίωση
- Δέρμα που γίνεται σφιχτό ή πρησμένο
Αυτές οι αλλαγές υποδηλώνουν ότι η λοίμωξη εξελίσσεται, όχι ότι υποχωρεί.

Τι πρέπει να κάνετε αμέσως;
Η έγκαιρη δράση μπορεί να αποτρέψει τις επιπλοκές.
- Διατηρήστε την περιοχή καθαρή: Πλύνετε απαλά με σαπούνι και νερό και αποφύγετε το έντονο τρίψιμο
- Μην πιέζετε ή σπάτε την κρούστα στην πληγή: Αυτό μπορεί να εξαπλώσει βακτήρια βαθύτερα στο δέρμα και να αυξήσει τον κίνδυνο επιπλοκών
- Καλύψτε την περιοχή: Χρησιμοποιήστε έναν καθαρό επίδεσμο για την πρόληψη της μόλυνσης και αλλάζετέ τον τακτικά.
Συμβουλευτείτε γιατρό εάν:
- Η λοίμωξη επιδεινωθεί εντός 1-2 ημερών
- Ο πόνος γίνει έντονος
- Εμφανίσετε πυρετό ή αισθάνεστε αδιαθεσία
Η έγκαιρη αντιμετώπιση μπορεί να περιλαμβάνει παρακέντηση υγρού και αντιβιοτική θεραπεία.
Πότε μια σταφυλοκοκκική λοίμωξη γίνεται σοβαρή;
Παρόλο που πολλές περιπτώσεις παραμένουν εντοπισμένες, οι σταφυλοκοκκικές λοιμώξεις μπορεί να γίνουν επικίνδυνες εάν εξαπλωθούν. Προειδοποιητικά σημάδια:
- Υψηλό πυρετός
- Ταχεία εξάπλωση ερυθρότητας
- Κόκκινες ραβδώσεις από το σημείο της μόλυνσης
- Κόπωση ή ζάλη
Σε σοβαρές περιπτώσεις, τα βακτήρια μπορούν να εισέλθουν στην κυκλοφορία του αίματος, οδηγώντας σε σοβαρές επιπλοκές.
Ποιος διατρέχει μεγαλύτερο κίνδυνο;
Ορισμένες ομάδες είναι πιο ευάλωτες, όπως άτομα:
- με εξασθενημένο ανοσοποιητικό σύστημα
- με διαβήτη
- με πρόσφατη χειρουργική επέμβαση ή τραύμα
- σε αθλήματα με επαφή δέρμα-με-δέρμα
- σε πολυσύχναστα περιβάλλοντα
Η έγκαιρη αναγνώριση των συμπτωμάτων είναι ιδιαίτερα σημαντική σε αυτές τις ομάδες.

Πώς μπορείτε να μειώσετε τον κίνδυνο μόλυνσης
Τα προληπτικά μέτρα επικεντρώνονται στην υγιεινή και την περιποίηση του δέρματος:
- Πλένετε τα χέρια σας τακτικά
- Διατηρείτε τις πληγές καθαρές και καλυμμένες
- Αποφύγετε την κοινή χρήση προσωπικών αντικειμένων (πετσέτες, ξυράφια)
- Καθαρίζετε τις επιφάνειες που αγγίζετε συχνά
Αυτά τα απλά βήματα μειώνουν την πιθανότητα εισόδου βακτηρίων.
Συχνές Ερωτήσεις
Μπορεί μια σταφυλοκοκκική λοίμωξη να υποχωρήσει από μόνη της;
Ορισμένες ήπιες δερματικές λοιμώξεις μπορεί να υποχωρήσουν, αλλά συνήθως απαιτούν ιατρική αξιολόγηση, ειδικά εάν επιδεινωθούν ή παράγουν πύον.
Είναι μεταδοτική μια σταφυλοκοκκική λοίμωξη;
Ναι. Μπορεί να εξαπλωθεί μέσω άμεσης επαφής με το δέρμα ή μέσω κοινόχρηστων αντικειμένων, ιδιαίτερα εάν οι πληγές δεν καλύπτονται.
Πόσο γρήγορα μπορεί να αναπτυχθεί μια σταφυλοκοκκική λοίμωξη;
Τα συμπτώματα μπορεί να εμφανιστούν μέσα σε λίγες ημέρες και μπορεί να επιδεινωθούν γρήγορα εάν δεν αντιμετωπιστούν.
Προκαλείται κάθε δερματικό έγκαυμα από σταφυλόκοκκο;
Όχι, αλλά τα βακτήρια του σταφυλόκοκκου είναι μια κοινή αιτία έγκαυμα και αποστήματος.
Συμπέρασμα
Οι σταφυλοκοκκικές λοιμώξεις συχνά ξεκινούν μικρές, αλλά δεν παραμένουν πάντα έτσι. Τα πρώιμα συμπτώματα όπως η ερυθρότητα, ο πόνος και ο σχηματισμός πύου είναι εύκολο να παραβλεφθούν, ωστόσο είναι κρίσιμα προειδοποιητικά σημάδια. Η γρήγορη δράση με την κατάλληλη φροντίδα και η γνώση του πότε να αναζητήσετε ιατρική βοήθεια μπορεί να αποτρέψει τις μικρές λοιμώξεις από το να γίνουν σοβαρά προβλήματα υγείας.
Πηγές:
cdc.gov
nhs.uk
clevelandclinic.org
mayoclinic.org
who.int

























